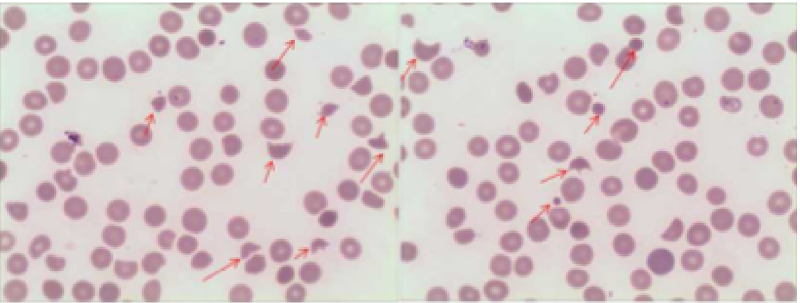
gln30-s5

HemaBook B?lĂŒm 4: Trombositopenide Daima Trombosit TransfĂŒzyonu Gerekli midir?
Mindray 2020-12-11

Trombosit (PLT) say?s? ?ok dĂŒ?ĂŒk oldu?unda, ger?ekten trombosit transfĂŒzyonu gerekli midir? Bize farkl? bir cevap veren a?a??daki durumu inceleyelim.
?
Vaka arka plan?
49 ya??nda bir kad?n, ge?ici kognitif bozukluk nedeniyle acil servise gitti. Kusma ve epigastrik a?r? ile birlikte bariz paroksismal ba? a?r?lar? vard?. Beyin BT'de herhangi bir anormallik g?rĂŒlmedi. Laboratuvar sonu?lar?nda anemi ve ?iddetli trombositopeni ortaya ??kt?. ?imdi ne beklenmeli?

Kan Testi
Kan testi (?ekil 1), 3.07Ă1012/L 'lik dĂŒ?ĂŒk RBC say?m? ve dĂŒ?ĂŒk HGB konsantrasyonu g?sterdi, bu da anemiyi i?aret etti. PLT-O say?s? 15Ă109/L (CDR modu, Mindray BC-6200) idi. Bu dĂŒ?ĂŒk bir PLT say?s? ve anormal RBC ile ilgili parametreler dikkatimizi ?ekti: Trombosit transfĂŒzyonu ba?lat?lmal? m??

PLT histogram? normal olanlardan uzakt?. Daha sonra birka? PLT noktas?n?n g?zlemlendi?i ve RET'in artt??? RET da??l?m diyagram?n? kontrol ettik (?ekil 2).

Bu anormal sonu?lar yeniden ?al??ma kural?n? tetikledi ve ard?ndan periferik kan yaymas? g?zden ge?irildi (?ekil 3). Sonu?, ?istositler, az say?da sferositler, kask hĂŒcreleri ve trombositopeniyi i?eren intravaskĂŒler hemoliz kan?t?n? g?sterdi.
?
Kemik ?li?i ?ncelemesi
Eritrosit hĂŒcre hatlar? %44, GranĂŒlositik hĂŒcre hatlar? %40, G/E = 0,91/1.
?
Kemik ili?i yaymas?nda farkl?la?mam?? eritroblastlar yayg?nd? ve Howell-Jolly g?vdesi bulundu. Yaymada toplam 257 megakaryosit bulundu ve 3 megakaryoblast, 44 promegakaryosit ve 3 ??plak nĂŒkleus megakaryosit dahil olmak ĂŒzere 50'si farkl?la?t?r?ld?. PLT nadiren g?rĂŒldĂŒ. Bu tĂŒr kemik ili?i yaymas?, megakaryositik trombositopeni, eritroid farkl?la?mas?n?n artm?? fonksiyonunu g?sterdi.
?
Biyokimya Testi
Biyokimya testinde total bilirubin (TBIL) sonucu artt?, indirekt bilirubin (IBIL) yĂŒkseldi ve hemolitik hastal?k g?sterdi.

Tipik semptomlar? olan vakalar dĂŒ?ĂŒnĂŒldĂŒ?ĂŒnde: (1) hemolitik anemi (?istositler); (2) trombositopeni; (3) n?rolojik semptomlar (ge?ici zihinsel bozukluk), trombotik trombositopeni (TTP) hastal??? olas?d?r. Sonu?lar ve TTP te?his ?nerisi derhal doktorlara aktar?ld?. Ve daha fazla ADAMTS13 testi TTP'yi onaylad?. Son olarak trombosit transfĂŒzyonu yerine plazma de?i?imi yap?ld?.

Sonu?
PLT seviyesi karar verme e?i?inin alt?ndaysa, deneyimli doktorlar numunenin uygun olup olmad???n?, histogram?n ve da??l?m grafi?inin normal olup olmad???n? ve di?er anormal hĂŒcre say?m sonu?lar?n? veya ?nemli mesajlar?, vb. hemen kontrol edeceklerdir. Daha fazla do?rulama, mikroskop alt?nda kan yaymas? incelemesi ile yap?lacakt?r. Son olarak, hastan?n semptomlar?n? ve t?bbi ge?mi? bilgilerini de?erlendirdikten sonra, laboratuvar sonu?lar? raporlayabilir ve olas? te?hisi sa?layabilir.

Mindrayâin otomatik 8x PLT-O say?m? (SF Cube teknolojisi), trombositopeni ?rnekleri i?in do?ru ve stabil say?m sa?lar. SC-120 Otomatik Periferik Yayma ve Boyama cihaz? yĂŒksek kaliteli kan yaymas?yla birlikte Mindray hematoloji ??zĂŒmleri, trombositopeninin etkin y?netimini destekler. PLT-O, Mindray BC-6000 Serisi Otomatik Hematoloji Analiz?rĂŒ ve CAL 8000/6000 Hemataloji Otomasyon Sistemleri serilerinde mevcuttur.
?
Uzant?: Trombotik trombositopenide neden trombosit transfĂŒzyonu ?nerilmiyor?
?
Trombositopeninin yayg?n nedenleri aras?nda kemik ili?inde ĂŒretimin azalmas?, periferik kanda artm?? y?k?m ve ila?lar?n sebep olmas?d?r[1].
?
Bu durumda TTP de dahil olmak ĂŒzere trombotik trombositopeni, artan PLT y?k?m?n?n neden oldu?u bir tĂŒr hastal?kt?r. Von Willebrand fakt?r (VWF) b?lĂŒnme proteaz (ADAMTS13) eksikli?i nedeniyle, VWF normal olarak kesilemez ve ultra bĂŒyĂŒk VWF (ULVWF) birikerek anormal PLT agregasyonu, mikrotromboz ve par?alanm?? RBC ile sonu?lan?r[2]. B?yle bir durumda trombosit transfĂŒzyonu, trombozu h?zland?rarak semptomlar?n k?tĂŒle?mesine yol a?abilir[3]. Bu nedenle trombotik trombositopeni i?in ana tedavi plazma de?i?imi olmal?d?r.
?
Te?ekkĂŒr:
?in Ganzhou Halk Hastanesi'nden Dr. Xiao Zuomiao, Dr. Chen Xianchun, Dr. Xiao Dejun ve Dr. Luo Shi'ye vaka bilgilerini sa?lad?klar? i?in te?ekkĂŒr ederiz.
Referanslar:
[1] What Is Thrombocytopenia? - NHLBI, NIH". www.nhlbi.nih.gov. Eri?im tarihi: 2015-05-01.
[2] Tsai, Han-Mou(2010). âPathophysiology of thrombotic thrombocytopenic purpura.â International journal of hematology cilt. 91,1: 1-19. doi:10.1007/s12185-009-0476-1.
[3] Joly, BS; Coppo, P; Veyradier, A (2017). "Thrombotic thrombocytopenic purpura." Blood. 129 (21): 2836â2846. doi:10.1182/blood-2016-10-709857.












